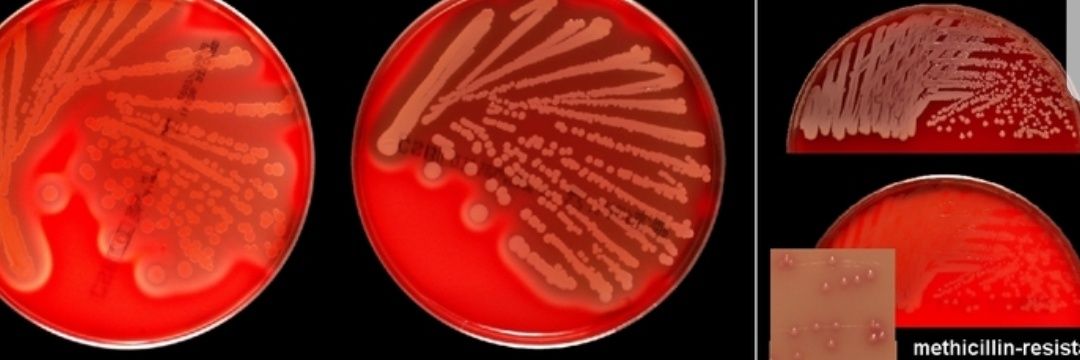
Yaw Collins banner

Yaw Collins retweetledi

Pep Guardiola: “What they have done, we have done it, they want it removed. They want to remove it. So we have to defend our position on the pitch”. 🔵 #MCFC
“It’s the only way we have to do it. What we have done all the time, all the time!”.

English